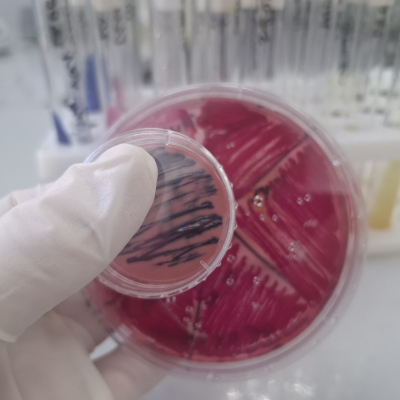
20250908_105946
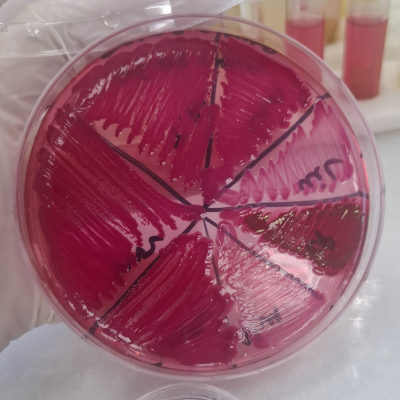
20250908_105900
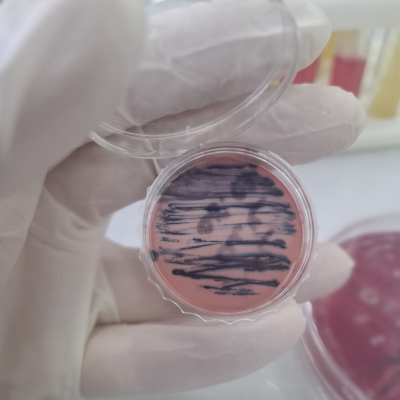
20250908_105916

В Краснодарский филиал ФГБУ «ВНИИЗЖ» на патологоанатомическое, а также на бактериологическое исследование поступил труп котенка породы ориентал, возраст 4 месяца.
При жизни животному был поставлен диагноз вирусный или инфекционный перитонит кошек (Feline Infectious Peritonitis, аббревиатура FIP, ИПК) - тяжелое инфекционное заболевание, сопровождающееся разнообразными признаками. Правильнее было бы называть патологию васкулит или полигрануломатозный полисерозит, так как она характеризуется воспалением сосудов или образованием гнойных гранулем (узелков) на брюшине. Вызывает заболевание РНК-содержащий коронавирус. Он является видоспецифичным, то есть патогенен только для домашних и диких кошачьих, а для других животных и человека безопасен. Вирус присутствует в организме многих кошек, но не всегда вызывает развитие патологического процесса. В данном случае произошла гибель животного.
При проведении исследования на условно-патогенную микрофлору обнаружена культура Citrobacter freundii, а также патогенная культура Klebsiella pneumoniae. Особое значение в данном случае играет клебсиелла, выделенная из крови, трубчатой кости, а также паренхиматозных органов кошки. Патогенность или способность вызвать заболевание у животных была подтверждена проведением биопробы на белых мышах. Klebsiella pneumoniae стала причиной осложнения основного заболевания, вирусного перитонита кошек, вызвала патологию различных систем организма, а как следствие полиорганную недостаточность и гибель животного.
Klebsiella pneumoniae
(палочка Фридлендера) — вид грамотрицательных факультативно -анаэробных палочковидных капсульных неподвижных бактерий, относящийся к роду клебсиелл. Встречается повсеместно в окружающей среде, в том числе в почве и поверхностных водах.Может вызывать различные инфекции, включая пневмонию, сепсис, инфекции мочевыводящих путей, бактериемию, менингит и абсцессы в печени. Инфицированию обычными штаммами чаще подвержены животные с иммунодефицитами, однако обнаруживаются и гипервирулентные штаммы, поражающие здоровых животных.
Встречается на медицинских приборах и является частой причиной внутрибольничных инфекций. Бактерия приобрела известность благодаря обнаружению связанных с ней тяжёлых инфекций и увеличивающемуся дефициту способов лечения. Всё чаще встречаются штаммы, которые устойчивы к антибиотикам, применяемым в крайних случаях.
Вторичная бактериальная инфекция у кошек возникает, когда ослабленная иммунная система (например, из-за вирусной инфекции) не может бороться с бактериями, приводя к появлению вторичных симптомов. Основные клинические признаки включают вялость, отказ от еды, повышение температуры, гнойные выделения из глаз и носа, а также расстройства желудочно-кишечного тракта. Важно обратиться к ветеринару при появлении любых признаках недомогания, поскольку эти инфекции могут быть опасными.
Причины возникновения:
Чаще всего вторичные инфекции развиваются у кошек с хроническими заболеваниями, такими как вирусный иммунодефицит (ВИК).
Некоторые вирусные инфекции снижают защитные силы организма, делая его уязвимым для бактериальных инфекций.
Кот становится сонливым, апатичным, теряет интерес к играм и еде
Температура тела может достигать 41°C.
Появляются гнойные выделения из глаз и носа.
Может наблюдаться рвота или диарея с неприятным запахом.
Дыхание может стать прерывистым.
Что делать при вышеперечисленных признаках?
Важно помнить, что кошки могут скрывать свое недомогание, поэтому при малейших изменениях в поведении или состоянии здоровья питомца следует обратиться к специалисту.
При поражении соответствующих систем возбудитель вторичной инфекции будет выделяться во внешнюю среду с экскретами (моча, фекалии и пр. выделения) и можно провести посев для бактериологического исследования, а также определения чувствительности выделенной микрофлоры к антибактериальным препаратам, что существенно облегчит тактику лечения ветеринарному врачу, а также поможет предотвратить необратимые последствия.
Качественную диагностику и бактериологические исследования на высоком профессиональном уровне выполнят для Вас специалисты КрИЛ ФГБУ «ВНИИЗЖ». Мы подберем наиболее чувствительные препараты к каждому возбудителю.
Будем рады видеть Вас в нашей лаборатории!